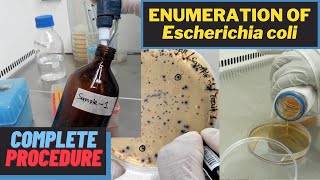

Enumeration of Escherichia coli (Total E. coli Count)_A Complete Procedure (ISO 9308-1 & ISO 16649)
Similar Tracks
Antibacterial Activity Test by Disk Diffusion Method_A Complete Procedure (Kirby and Bauer Method)
MicroChem's Experiments
Total Yeast & Mold Count (Total Fungal Count)_A Complete Procedure (BAM, Ch-18)
MicroChem's Experiments
Detection of Escherichia coli (E. coli)_A Complete Procedure (ISO 9308-1 & ISO 16649)
MicroChem's Experiments
Four Quadrant Streak procedure - How to properly streak a Petri plate for isolated colonies
Hardy Diagnostics
Total Plate Count (Total Aerobic Bacterial Count)_A Complete Procedure (BAM, Ch-3)
MicroChem's Experiments
Detection of Salmonella species in Different Samples (Part-1)_A Complete Procedure (ISO 6579-1:2017)
MicroChem's Experiments
Culture Media Preparation | For Microbiological Analysis | Agar Media Plate | BAM
MicroChem's Experiments
Enumeration of Staphylococcus aureus in Food | A Complete Procedure | BAM, Chapter-12
MicroChem's Experiments